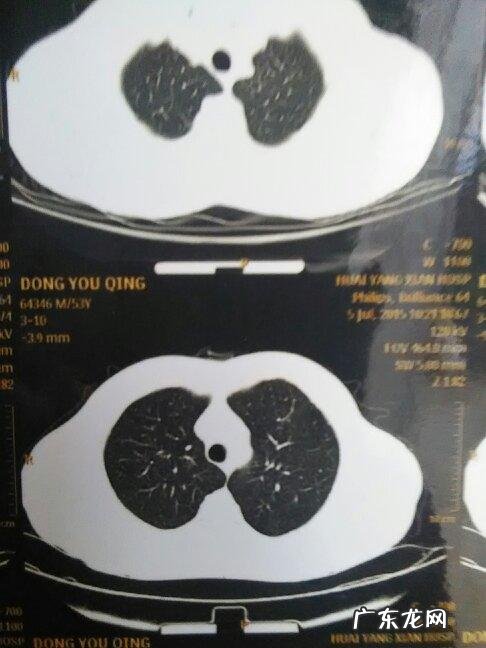

【肺部有白点问题大不大?医生告诉你:这2类人最好去医院看看!】
文章插图
生活中我们经常会听到关于肺部有白点的说法,那么在肺部有白点问题大不大呢?肺癌的症状是什么?我们应该怎么做呢?一起来看看吧 。
一、肺癌的症状:肺癌早期症状不典型,容易被忽视 。因此,对于经常出现的咳嗽、咳痰现象,要注意排除肺癌的可能性 。由于肺癌可引起肺部的病变,导致肺部出现感染,所以也会出现一些症状 。例如出现痰中带血或者是带血 。早期肺癌可能只是咳嗽的情况出现,但是随着病情的发展,症状会越来越严重,而且还会出现一些并发症 。因此当出现这些症状时应当及时到医院进行相关检查 。
二、肺癌的症状不一样肺癌早期,肺癌的症状是不一样的 。早期肺癌的症状是比较轻的,像咳嗽没有痰,并且胸部出现疼痛,有一定的癌性 。如果不是由于肿瘤的侵犯肺部而引起,而发生癌性咳嗽或者是咳痰这样的症状,这时候肺癌比较严重,还有可能引起胸痛以及呼吸困难,这是比较严重的一种肺部问题,如果是肺癌要引起重视的 。是会出现咳血的现象 。同时可以通过吸烟或者其他原因导致的肺癌患者会出现咳嗽,呼吸困难和胸痛现象 。并且在严重情况下 。
三、肺癌的症状和治疗肺癌的症状比较的多,如果发现自己有咳嗽咳痰,咯血,胸痛,呼吸困难等症状,要及时到医院进行检查,如果不及时治疗的话,很可能会发展成肺癌 。而且有一些肺癌是很容易出现胸痛的情况的,如果出现胸痛,也要及时就医,在肺癌的治疗上也是很重要的,治疗肺癌主要是手术治疗和放化疗 。对于那些没有任何症状,同时也没有肺部感染的患者来说,治疗的效果并不好,所以需要大家去注意治疗 。而且要注意的是,对于有家族史、有肺癌病史或是长期吸烟的人群来说,应该定期去医院进行肺部检查以免被肺癌给骗了 。
四、肺癌的治疗肺癌的治疗方式主要有手术、化疗、放疗、靶向治疗和免疫治疗 。根据不同的类型,选择不同的治疗方式 。手术主要用于早期肺癌,对早期肺癌疗效较好,手术范围较小而局限的患者,一般不需要放疗,也不需要化疗 。化疗可以控制肿瘤持续生长,延长患者生命 。手术可以彻底清除肿瘤以及转移病灶,达到临床治愈的目的 。化疗主要用于原发性肺癌手术切除后放疗,患者生存期可达2-3年之久 。化疗后可以根据不同的治疗情况来决定后续能否进行靶向治疗 。如果患者手术后复发,则必须进行第二次治疗 。另外化疗有很好的疗效 。在进行化疗前应积极进行相关检查,因为这样可以更好地避免肿瘤扩散 。
- 男士休闲西服品牌有哪些
- 让键盘出现电脑屏幕,这样玩太有趣了!
- 肚子刮痧减肥有效吗 刮痧减肥多久一次好
- 柴犬和土狗有什么区别 柴犬是土狗吗
- 肺部变白要命吗?肺脏变白的危害有哪些?听听医生怎么说!
- 酱油上面有泡沫正常吗 酱油是有泡沫好还是没泡沫好
- 吴江区有哪些镇?看看这个就知道!
- 泡泡玛特盲盒是什么 肯德基泡泡玛dimoo盲盒有哪几款
- 疫情对中国2022冬奥会有哪些影响 2022冬奥会期间有哪些防疫黑科技
- 水乳早上用还是晚上用 早上用水乳和晚上用水乳各有好处
特别声明:本站内容均来自网友提供或互联网,仅供参考,请勿用于商业和其他非法用途。如果侵犯了您的权益请与我们联系,我们将在24小时内删除。
